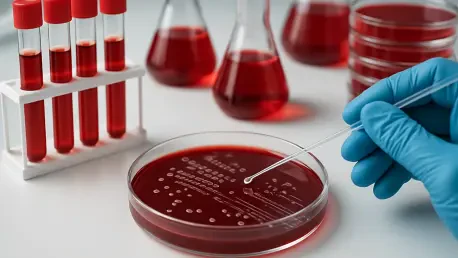
Científicos Cultivan la Sangre Más Rara del Mundo en Laboratorio

En un mundo donde millones de vidas dependen de las transfusiones sanguíneas cada año, existe un tipo de sangre tan escaso que solo unas 50 personas en todo el planeta lo poseen, conocido como sangre Rh nulo o «sangre dorada». Su valor radica en su capacidad de ser compatible con cualquier grupo sanguíneo dentro del sistema Rh, lo que la convierte en un recurso invaluable para emergencias médicas. Este avance científico, liderado por investigadores de diversas partes del mundo, plantea una revolución en la medicina transfusional al intentar cultivar esta sangre en laboratorio, enfrentando desafíos técnicos y éticos de enorme magnitud. La posibilidad de fabricar un suministro ilimitado de sangre ultracompatible abre un horizonte esperanzador para pacientes con tipos raros y situaciones críticas donde el tiempo es un lujo inalcanzable.
Contexto y Relevancia de la Investigación sobre la Sangre Rh Nulo
Las transfusiones sanguíneas han sido un pilar de la medicina moderna desde hace décadas, permitiendo salvar vidas en cirugías, accidentes y tratamientos de enfermedades graves como el cáncer. Sin embargo, las incompatibilidades inmunológicas entre donantes y receptores representan un obstáculo constante, ya que una transfusión errónea puede desencadenar reacciones fatales. La sangre Rh nulo, al carecer de los 50 antígenos del sistema Rh, emerge como una solución potencial al ser un donante prácticamente universal dentro de este sistema, capaz de beneficiar a pacientes sin importar su grupo sanguíneo específico en dicho contexto.
Este tipo de sangre resulta especialmente crucial para personas con combinaciones raras de antígenos, quienes a menudo enfrentan dificultades extremas para encontrar donantes compatibles. Además, en emergencias donde no hay tiempo para determinar el grupo sanguíneo del paciente, la sangre Rh nulo podría marcar la diferencia entre la vida y la muerte. Su relevancia se extiende también a grupos étnicos con mayor diversidad de antígenos Rh, que frecuentemente luchan por acceder a sangre compatible en sistemas de donación tradicionales.
La importancia social de este avance no puede subestimarse, ya que promete reducir desigualdades en el acceso a tratamientos médicos vitales. Al cultivar sangre Rh nulo en laboratorio, se busca no solo superar la escasez de donantes, sino también garantizar transfusiones más seguras y accesibles, especialmente en regiones con recursos limitados o poblaciones diversas. Este proyecto representa un paso hacia una medicina más inclusiva, atendiendo necesidades que hasta ahora han sido desatendidas.
Metodología, Hallazgos e Implicaciones de la Investigación
Metodología
Para lograr el cultivo de sangre Rh nulo, los científicos han recurrido a tecnologías de vanguardia que incluyen el uso de células madre y la edición genética mediante CRISPR-Cas9. Estas técnicas permiten modificar glóbulos rojos inmaduros para eliminar los genes responsables de los antígenos problemáticos del sistema Rh, replicando un tipo de sangre que naturalmente es extremadamente raro. Equipos de investigación de la Universidad de Bristol, la Universidad Laval en Canadá y centros especializados en Barcelona, España, han liderado estos esfuerzos con enfoques complementarios.
Un aspecto clave del proceso consiste en emular la maduración natural de los glóbulos rojos, un fenómeno que ocurre en la médula ósea bajo condiciones biológicas específicas. En el laboratorio, este desarrollo se enfrenta a múltiples obstáculos, ya que las señales necesarias para la maduración son difíciles de reproducir artificialmente. Los investigadores han experimentado con líneas celulares derivadas de donantes con sangre Rh nulo, buscando establecer un suministro sostenible que no dependa de donaciones constantes.
Además, se han implementado estrategias para transformar sangre de otros grupos, como el tipo A, en sangre O Rh nulo, eliminando antígenos específicos mediante herramientas genéticas precisas. Este enfoque no solo amplía las posibilidades de producción, sino que también demuestra la versatilidad de las tecnologías actuales para abordar problemas de compatibilidad. Los protocolos desarrollados se someten a rigurosas pruebas para garantizar la seguridad y eficacia antes de cualquier aplicación clínica.
Hallazgos
Los resultados obtenidos hasta ahora son prometedores, destacando la creación exitosa de sangre Rh nulo en entornos controlados de laboratorio. Los investigadores han logrado producir glóbulos rojos libres de antígenos Rh a partir de células madre, un paso crucial hacia transfusiones universales dentro de este sistema. Asimismo, se ha conseguido transformar sangre de tipo A en O Rh nulo, ampliando las fuentes potenciales para este recurso médico tan escaso.
Un hito importante es el ensayo clínico RESTORE, que evalúa la seguridad de transfundir glóbulos rojos cultivados en laboratorio a voluntarios sanos. Este estudio representa un avance significativo al probar la viabilidad de estas células en condiciones reales, sentando las bases para aplicaciones futuras. Los datos preliminares sugieren que las células cultivadas pueden funcionar de manera similar a las naturales, aunque aún se requieren más análisis para confirmar su estabilidad a largo plazo.
Otro logro destacado es el desarrollo de líneas celulares a partir de donaciones de personas con sangre Rh nulo, permitiendo una producción teóricamente indefinida de glóbulos rojos compatibles. Este enfoque reduce la dependencia de donantes específicos y abre la puerta a bancos de sangre artificiales que podrían atender emergencias globales. Estos hallazgos refuerzan la idea de que la sangre cultivada podría complementar, y en algunos casos sustituir, los sistemas tradicionales de donación en el futuro.
Implicaciones
La capacidad de producir sangre Rh nulo en laboratorio tiene implicaciones prácticas de gran alcance, especialmente en el ámbito de las transfusiones de emergencia. Al garantizar un suministro de sangre compatible con cualquier receptor del sistema Rh, se podrían evitar complicaciones inmunológicas en situaciones críticas, salvando innumerables vidas. Este avance es particularmente relevante para pacientes con tipos de sangre raros, quienes a menudo dependen de búsquedas internacionales para encontrar donantes adecuados.
Desde una perspectiva social, esta innovación podría tener un impacto desproporcionado en comunidades con alta diversidad genética, como ciertas minorías étnicas, que enfrentan mayores desafíos de compatibilidad. La sangre cultivada promete reducir estas barreras, asegurando que más personas tengan acceso a tratamientos médicos sin importar su perfil sanguíneo. Además, podría aliviar la presión sobre los bancos de sangre tradicionales, especialmente en regiones con escasez crónica de donantes.
Sin embargo, las implicaciones éticas no deben pasarse por alto. La edición genética, aunque poderosa, plantea preguntas sobre la seguridad a largo plazo y los posibles efectos no deseados en las células modificadas. Antes de que esta tecnología pueda implementarse a gran escala, es fundamental establecer regulaciones estrictas y realizar ensayos clínicos exhaustivos para garantizar que los beneficios superen los riesgos. Este equilibrio entre innovación y precaución será clave para su aceptación en la práctica médica.
Reflexión y Direcciones Futuras del Proyecto
Reflexión
El camino hacia la producción de sangre Rh nulo en laboratorio ha estado marcado por avances significativos, pero también por desafíos técnicos considerables. Replicar el proceso natural de maduración de los glóbulos rojos fuera del cuerpo humano sigue siendo una tarea compleja, ya que las condiciones del laboratorio no pueden imitar completamente las señales biológicas de la médula ósea. Este obstáculo ha requerido ajustes constantes en los protocolos experimentales para mejorar la viabilidad de las células producidas.
Otro punto de análisis es el costo y la escalabilidad de estas tecnologías. Actualmente, el cultivo de sangre artificial es un proceso intensivo en recursos, lo que limita su accesibilidad a nivel global. Aunque se han logrado progresos en la optimización de las líneas celulares, la producción masiva sigue siendo un objetivo lejano, lo que subraya la necesidad de encontrar soluciones económicas sin comprometer la calidad o la seguridad de las transfusiones.
Finalmente, cabe reflexionar sobre el alcance de la investigación actual, que se ha centrado principalmente en el sistema Rh. Si bien este enfoque es comprensible dado el impacto de los antígenos Rh en las reacciones inmunológicas, otros sistemas de antígenos, como Kell o Duffy, también pueden causar complicaciones significativas. Expandir el espectro de la investigación para abordar estas variables podría maximizar el impacto de la sangre cultivada en un contexto más amplio de compatibilidad.
Direcciones Futuras
Mirando hacia adelante, es esencial priorizar el desarrollo de métodos más eficientes para la producción de sangre cultivada, reduciendo tanto los costos como el tiempo necesario para su fabricación. Innovaciones en bioreactores y técnicas de cultivo podrían permitir una escalabilidad que haga viable su uso en hospitales y clínicas de todo el mundo, especialmente en regiones con sistemas de salud limitados. Este esfuerzo requerirá inversiones significativas y un enfoque multidisciplinario.
Otra línea de investigación prometedora es la aplicación de estas tecnologías a otros tipos de sangre raros, como el fenotipo Bombay, que presenta desafíos de compatibilidad aún más extremos. Al abordar una gama más amplia de antígenos y sistemas sanguíneos, se podría avanzar hacia una verdadera sangre universal que elimine prácticamente todas las barreras inmunológicas. Este objetivo, aunque ambicioso, podría transformar por completo el panorama de las transfusiones médicas.
Por último, la colaboración entre instituciones académicas, gobiernos y empresas privadas será crucial para acelerar el desarrollo y la implementación de estas soluciones. Iniciativas conjuntas podrían facilitar el financiamiento de ensayos clínicos a gran escala y la creación de bancos de sangre artificial, garantizando que los beneficios de esta tecnología lleguen a quienes más los necesitan. Este espíritu de cooperación será determinante para superar los retos pendientes y llevar la sangre cultivada del laboratorio a la práctica cotidiana.
Conclusión: El Futuro de la Sangre Cultivada y su Impacto Global
Los esfuerzos para cultivar la sangre Rh nulo en laboratorio han marcado un hito en la medicina transfusional, al demostrar que es posible replicar un recurso tan raro y valioso como la «sangre dorada». Los avances en edición genética y cultivo celular han ofrecido una visión de transfusiones más seguras y accesibles, especialmente para pacientes con tipos sanguíneos poco comunes y en emergencias críticas. Sin embargo, los desafíos técnicos y éticos, desde la complejidad de la maduración celular hasta las regulaciones necesarias, evidencian que el camino hacia la implementación clínica aún requiere un trabajo exhaustivo.
Como siguiente paso, sería fundamental establecer alianzas globales para financiar y estandarizar la producción de sangre artificial, asegurando que su costo no limite su alcance a países desarrollados. Además, sería prioritario diseñar campañas educativas que informen a la población sobre la importancia de las donaciones tradicionales mientras estas innovaciones se perfeccionan. Finalmente, un enfoque en la personalización de la sangre cultivada para grupos específicos podría garantizar que nadie quede excluido de los beneficios de esta revolución médica, consolidando un futuro donde la compatibilidad sanguínea deje de ser una barrera para salvar vidas.